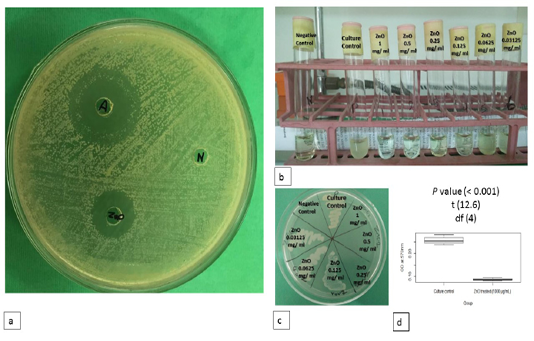

Advances in Animal and Veterinary Sciences
Antimicrobial activity of ZnO NPs. a) Antimicrobial activity of ZnO NPs on MHA. b) MIC of ZnO NPs against S. parauberis on MHB. c) MBC of ZnO NPs against S. parauberis on antibiotic free TSA. d) Cell viability after treatment with ZnO NPs using TTC assay. Positive and negative controls are indicated.
Transmission electron microscopy (TEM) of ZnO NPs. (a and b) the shape of the synthesized ZnO NPs under TEM. TEM image of S. parauberis cultured in the absence (c) and presence (d) of chemically synthesized ZnO NPs. e) ZnO NPs attached to the bacterial cell membrane and appeared intracellularly. The scale bars are indicated.